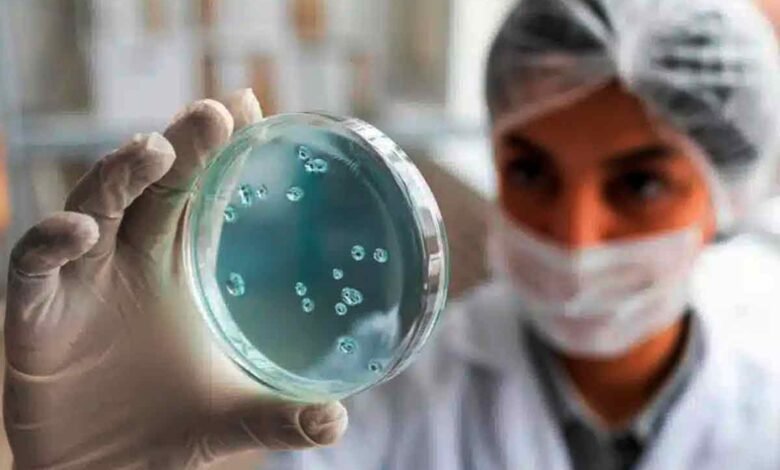

» Estilo
Representando os mais de 3,5 mil
Laboratório Teuto premia os 78 colaboradores mais longevos, em comemoração ao 78º aniversário
▻7Minutos
» Economia
Compromisso com a sustentabilidade
Coca-Cola Bandeirantes realiza entrega de uniformes
▻7Minutos
» Economia
Estadão Economia Negócios
Onde é mais rentável ter imóvel para locação de curta duração? Veja ranking de cidades
▻Estadão
» Notícias
Complementação da segurança
Projeto quer integrar imagens de câmeras de residências, empresas e órgãos públicos
▻Jornal Contexto
» Estilo
Localizada em Pirassununga (SP).
FAB terá oportunidade para mulheres na Infantaria pela primeira vez
▻Jornal Contexto
» Estilo
Vander Lúcio comenta no 7Minutos
O peso da incerteza que adoece o brasileiro
▻Jornal Contexto
» Notícias
Política Brasil
Bolsonaro deve ser transferido para hospital em Brasília, diz senador
▻7Minutos
» Estilo
Nos dias 12 e 13 de abril,
Feira da Páscoa chega à quarta edição unindo arte, cultura, fé e solidariedade
▻7Minutos
» Notícias